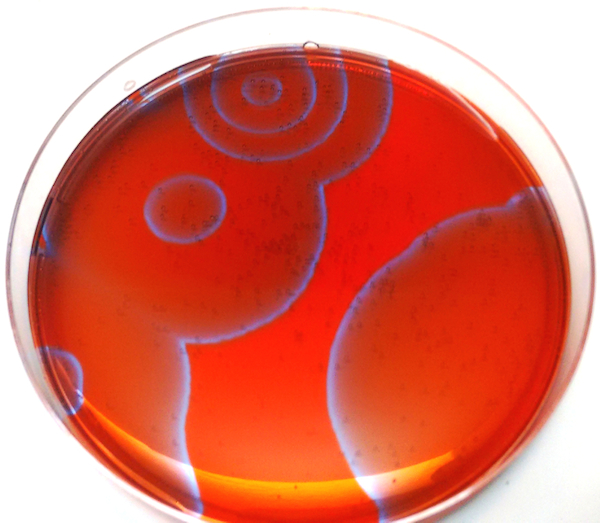
Refer to caption

2cm2cm.3cm2cm
The dry history of liquid computers
University of the West of England, Bristol, UK
andrew.adamatzky@uwe.ac.uk)
Abstract
A liquid can be used to represent signals, actuate mechanical computing devices and to modify signals via chemical reactions. We give a brief overview of liquid based computing devices developed over hundreds of years. These include hydraulic calculators, fluidic computers, micro-fluidic devices, droplets, liquid marbles and reaction-diffusion chemical computers.
1 Introduction
A substance offering no resistance to a shear deformation is a fluid. A liquid is an incompressible fluid. Our personal interest in liquid based computers started in early 1990s where we proposed a paradigm and experimental laboratory implementations of reaction-diffusion chemical computers [3, 12], affective liquids [1] and liquid brains for robots [18, 22]. In reaction-diffusion computers information is processed via interaction of phase or diffusion wave fronts. Affective liquids are mixtures of chemical species representing emotional states [1], and stirred or thin-layer mixtures of doxastic and affective chemical-like species [26]. Liquid brain for robots are onboard controllers for robot navigation which employ a thin-layer excitable chemical reaction [6].
| Year | Device | Publications |
|---|---|---|
| 1900 | Hydraulic algebraic machines | [56, 62, 58] |
| 1920 | Tesla diode | [115] |
| 1936 | Hydraulic integrators | [90, 86] |
| 1949 | Monetary National Income Analogue Computer | [37] |
| 1949 | Fluid mappers | [91] |
| 1960 | Fluidic logic | [72, 100, 98, 52, 39] |
| 1985 | Belousov-Zhabotinsky computers | [81, 27, 110, 68, 12] |
| 1996 | Reaction-diffusion computers | [4, 118, 25, 2] |
| 2003 | Liquid brain for robots | [18, 19] |
| 2003 | Fluid maze solver | [60] |
| 2007 | Droplet logic (pressure/flow driven) | [42, 57, 117, 101] |
| 2010 | Chemotactic droplets solving mazes | [82, 41] |
| 2012 | Droplet logic | [88] |
| 2017 | Liquid marbles logic | [53] |
A chronological order of selected liquid based computing devices is shown in Tab 1. Most of the prototypes are discussed in the paper. In these devices liquid is used in various roles. Mass transfer analogies are employed in hydraulic mathematical machines in Sect. 2 and integrators Sect. 3. Flows of fluid explore and map templates, and solve mazes, in fluid mappers, Sect. 4. In Sect 4 the fluid flow is driven by the fluid pressure. A fluid flow can be also evoked by temperature and chemical concentration gradients, and then visualised by travelling liquid droplets, as shown in Sect. 5. Interacting fluid jets realise logical gates in fluidic logic devices in Sect. 6, where Boolean values are represented by a flow pressure in the channels. In Sect. 8 The liquid is discretised in droplets and liquid marbles and computation is implemented via liquid marbles colliding with each other or actuating mechanical devices. Oxidation wave fronts or diffusing fronts of precipitation solve logical and computational geometry problems in the reaction-diffusion computers in Sect. 9.
The examples discussed demonstrate versatility of the liquid as a computing substrate. We hope the overview will encourage researchers and engineers to be more proactive in employing the liquid phase in their unconventional computing devices.
2 Hydraulic algebraic machines




In 1901 Arnold Emch published a paper in The American Mathematical Monthly where he a proposed to calculate the th root of any number by immersing solid bodies in a liquid [56]. He assumed a paraboloid shape body is immersed in a liquid as shown in Fig. 1. When this body is immersed a weight of the displaced water will be , where is a weight of one cubic foot of water. The function is selected such that the weight of the displaced water equals to th power of a given number : .
A device for the extraction of a square root of a given number is shown in Fig. 1. is a hook-gauge showing a water level. The shape of the parabolic body immersed is defined by equation . Let be a weight of the water displaced, be a weight of the vessel, and be an added weight to make . Thus, . The value is measured by gauge as a difference of the water levels before and after the immersion.
A method of solving trinomial equation , where is a constant, was proposed by Demanet, cited by [62]. The device shown in Fig. 1 is an inverted cone joined with a cylinder, base is one square centimeter, with a tube. Height of the cone and the cone’s radius are selected so that . A cm2 of water poured into the device will stay at the height in both vessels. Volume of the water in a cylinder will be (because ). Volume of the water in the cylinder used in the device is . Thus we have . The height of the water is the solution of the equation.
A hydrostatic balance, inspired by [56], was proposed by Meslin [62] to solve the equation (Fig. 1 [62]). Solid bodies are immersed in a liquid. Parameters of the bodies are selected so that when units of length are immersed in the liquid the volumes are proportional to . Coefficients , etc. are represented by distances of the bodies’ hanging points relative to the axis of rotation of the beam (left means negative and right positive). After bodies are immersed a weight is suspended at a unit distance from the axis of rotation. The system becomes temporarily disturbed but the equilibrium is restored by the water redistribured between the vessels. After that the moments of the bodies relative to the axis of rotation of the beam will be , and therefore is the solution found.111The hydraulic equation solvers are discussed in the context of electrical and mechanical solvers in [58].
3 Hydraulic integrators


In early 1930s hydraulic computing devices have been invented simultaneously in USSR by Luk’yanov [86] and in USA by Moore [90]. Both were designed to imitate heath transfer not by solving differential equations by hand or existing calculators but by the analog modelling of the heat propagation with water (Fig. 2). The devices relied on the following analogies between liquid and thermal characteristics of thermoconductive building materials [90, 86, 31]. Levels of water in vessels represent difference of temperatures of the building materials and the air. Cut area of the vessels represents a thermal capacity of layers. Hydraulic resistance of the tubes connecting the vessels is analogous to the thermal resistance of the simulate material layers.
As stated by Polytechnic Museum (Moscow, Russia) [116] there were c. 150 hydraulic integrators produced in USSR, some exported to Poland, Czech Republic and China. A portable version of Lukyanov integrator was manufactured for schools. Moore’s hydrocal was deployed for studies on heat transfer in geological constructions.
Over a decade after the invention and relatively wide usage of the hydraulic integrators, in late 1940s, Phillips designed and prototyped his Monetary National Income Analogue Computer (MONIAC), also known as Phillips Hydraulic Computer (Fig. 2). There a flow of money was imitated by a redistribution of water between the containers [37].
4 Fluid mappers and maze solvers
In 1900 Hele-Shaw and Hay proposed an analogy between stream lines of a fluid flow in a thin layer and the lines of magnetic induction in a uniform magnetic field [70]. They applied their ideas to solve a “problem of the magnetic flux distortion brought about by armature teeth” [71]. In 1940s Hele-Shaw and Hay analogies were advanced by Arthur Dearth Moore who developed fluid flow mapping devices [91].





The Moore’s fluid mappers were made of a cast slab, covered by a glass plate, with input (source) and output (sink) ports. Crystals of potassium permanganate or methylene blue were evenly distributed at the bottom of the slab. Fluid flow lines were visualised by traces from the dissolving crystals. Moore shown that the fluid mappers can simulate electrostatic and magnetic fields, electric current, heat transfer and chemical diffusion [91]. The fluid mappers became popular, for a decade, and have been used to solve engineering problems of underground gas recovery and canal seepage [92], current flow modelling in human body [87] (Fig. 3a) and design of fume exhaust hoods [44] (Fig. 3b).
The Moore’s fluid mappers could solve mazes, however Moore never reported this. A first published evidence of an experimental laboratory fluid maze solver is dated back to 2003. In the fluidic maze solver developed in [60] a maze is the network of micro-channels. The network is sealed. Only the source site (inlet) and the destination site (outlet) are open. The maze is filled with a high-viscosity fluid. A low-viscosity coloured fluid is pumped under pressure into the maze, via the inlet. Due to a pressure drop between the inlet and the outlet liquids start leaving the maze via the outlet. A velocity of the fluid in a channel is inversely proportional to the length of the channel. High-viscosity fluid in the channels leading to dead ends prevents the coloured low-viscosity fluid from entering the channels. The shortest path — least hydrodynamic resistance path — from the inlet to the outlet is represented by the channels filled with coloured fluid (Fig. 3c). Similar approach could be used to solve maze at a macro scale, e.g. with milk and water (Fig. 3d) or milk and coffee (Fig. 3e).
5 Droplets tracing fluid mappers
A motion of a droplets of one liquid in another liquid is determined by thermal and chemical gradients, and directed by flows outside and inside the droplet [131, 83, 65, 66, 125, 130]. If the gradients represent a solution of a computational problem then droplets travelling along the gradients might be seen as solving the problem. Such an experimental prototype of a droplet traversing pH gradient is presented in [82]. There a polydimethylsiloxane maze is is filled with a solution of potassium hydroxide. Surfactant is added to reduce the liquids surface pressure. An agarose block soaked in a hydrochloric acid is placed at a destination site. A pH gradient establishes in the maze. Then a droplet of a mixture of mineral oil or dichloromethane with 2-hexyldecanoic acid is placed at the start site. The droplet is not mixed with solution filling the channels. The droplet travels along the steepest gradient of the potassium hydroxide. The steepest gradient is along the shortest path. Therefore the droplet travels from its start site to the destination site along the shortest path [82].
Exact mechanics of the droplet motion is explained in [82] as follows. Potassium hydroxide, which fills the maze, is a deprotonating agent. Molecules of the potassium hydroxide remove protons from molecules of 2-hexyldecanoic acid diffusing from the droplet. A degree of the protonation is proportional to the concentration of hydrochloric acid diffusing from the destination site. The protonated 2-hexyldecanoic acid at the liquid surface determines the surface tension. The gradient of the protonated acid determines a gradient of the surface tension. The surface tension decreases towards the destination site. A flow of liquid — the Marangoni flow — is established from the site of the low surface tension to the site of the high surface tension. The droplet is moved by the flow [82]. The flow of liquid between two sites of the maze have been also visualised with A dye powder, Phenol Rd, placed as the start site [85]. The Marangoni flow transports the dye form the start to the destination. The coloured channels represent a path connecting the start and the destination. This type of visualiation has been already in connection with Moore’s fluid mappers in Sect. 4.






Another prototype of chemotactic droplet maze solver is demonstrated in [41]. The maze is filled with a water solution of a sodium decanoate. A nitrobenzene droplet loaded with sodium chloride is placed in the destination site. A decanol droplet is placed at the start site. The sodium chloride diffuses from the its host nitrobenzene droplet in the destination site. A gradient of the saline concentration is established. The gradient is steepest along a shortest path leading from any site of the maze to the destination. The decanol droplets move along the steepest gradient till it reaches the droplet at the destination site (Fig. 4).
The experimental prototypes of travelling droplets laid the foundation of an emergent field of liquid robots [40, 43]. There droplets are studied as adaptive actuating and/or propulsive devices capable for navigation in a dynamically changing environments.
While talking about mobile droplets we must mention that liquid droplets of Belousov-Zhabotinsky reaction (Sect. 9) are known to exhibit spontaneous motion [78, 79, 89, 113] due to convention processes coupled with oxidation waves. However, we are not aware of any programmable information processing tasks being implemented by the mobile BZ droplets (a computation with stationary BZ droplets is discussed in Sect. 9).
6 Fluidic logic
Fluids have been used for centuries to transmit force and energy in mechanical systems. First works on using fluids for computation are traced back to late 1950s early 1960s [77, 95, 45]. The basic principles of the fluidic devices are the laminar flow of a fluid, a jet interaction, a wall attachment and a vortex effect. The jet interaction is the phenomenon where fluid flows are arranged so that small opposing jets experience changes of direction which can be used as output signals. The wall attachment phenomenon is that the fluid attaches to a surface within a device and continues to flow over the surface until disturbed. First devices designed and fabricated in 1960s included the beam deflection, turbulence, vortex and wall attachment amplifiers, the and, not, or and xor logical elements, counters and shift registers. The fluidic devices have been used in jet sensing, programmable sequence control, flameproof equipment, machine tools control, systems operating nuclear reactor coolant, servo-control in marine applications, missile and aircraft control, artificial heart-pump, lung ventilator [77, 95, 45].












The and-not gate is the most known, a par with a bistable amplifier, devices in the fluidics (Fig. 5a). Two nozzles are placed at right angles to each other. When there are jet flows in both nozzle they collide and merge into a single jet entering the central outlet. If the jet flow is present only in one of the input nozzles it goes into the vent. Horizontal output channel implements and and later channels and not and not and .
A monostable beam deflection device is comprised of a power supply, controls/inputs and vents (Fig. 5bc). When no inputs are present the fluid jet from the power source exits through the output (Fig. 5b). When one or both input jets are present, the jet from the power source is deflected into the vent and discharged (Fig. 5c) [77]. The fluid jet exits the output only if none of the input jets are present. This is nor operation.
The monostable beam deflection device (Fig. 5bc) can be transformed into nor-or gate (Fig. 5d) by adding an output outlet instead of the vent [55]. When no control jets are present the jet from the power source exits via the outlet . If one or both signal jets are present, the jet from the power source is deflected in the outlet .
A fluidic diode is a two-terminal device which restricts, or even cancels, flow in one direction (backward direction). Tesla diode [115] (Fig. 5e) and scroll diode [98, 77] (Fig. 5f) are most known fluidic diodes (as well as vortex diode which is not discussed here).
The Tesla diode (Fig. 5e), called the ‘valvular conduit’ by its inventor [115], is composed of buckets and partitions arranged in such a manner that the forward flow propagates mainly along axis (4 to 5 in Fig. 5e). In the backward direction (5 to 4 in Fig. 5e) fluid enters the branches and loops around to oppose the main flow.
In the fluidic scroll diode (Fig. 5f) the channel, or nozzle, is converging in the backward direction and enters an annular cap. In the forward direction the fluid flows through the throat and into a diffuser section. In the backward direction the fluid enters the cap and is directed back towards an incoming flow, causing a turbulence.
A delay in the fluidic systems is implemented as volumetric tank (Fig. 5g) with input and output pipes. A step change in the input pressure on the input appears as a similar change in the output pressure on the output after a delay. The delay is caused by the turbulence. The amount of the delay is determined by the volume of the tank [52]. Another version of a delay element (Fig. 5h) combines orifices and volumes to have a low impedance in one direction of the flow (from the left to the right in Fig. 5h) and a high impedance in the opposite direction of the flow (from the right to the left) [39]. The impedance provides a phase shift during transient flow. The phase shift contributes to the retarding of the fluid flow, thus introducing a time delay of the flow. The device can also act as a diode and a pressure divider.
A fluidic one-bit half-adder can be implemented on the basis of the gate proposed by Hobbs in 1963 [72] (Fig. 5). Logical values are encoded into presence of streams at the specified channels. When only input is True, a power jet stream enters the gate via channel . The stream is turned by the hook and follows the channel (Fig. 5). When only input the power jet stream entering the gate via channel locks on (gets attached to) the left boundary wall of its channel, and propagates along the channel (Fig. 5). If both inputs are True streams entering and merge and follow the channel (Fig. 5). Thus the stream exiting the channel represents and the stream exiting the channel represents .
7 Digital microfluidic logic








In fluidic logic devices fluid jets are programmed by geometry of channels and perform computation by interacting with each. Boolean values are represented by pressure of the jets in the output channel. In digital microfluidcs signals are represented by droplets or bubbles travelling in the channel [57, 117, 88, 42]. The droplets/bubbles also control pressure in the channels thus affecting trajectories of other droplets/bubbles. Example a fluidic gate, designed in [42], with two inputs and two outputs is shown in Fig. 6-6. An oil droplet is in aqueous phase. When a droplet enters a channel with the largest flow rate, a pressure drop increases across the channel containing two-phase emulsions, particularly at a low capillary number.
Cheow et al. [42] designed a ratio of tubes and flows (Fig. 6) such that the following phenomena take place. A flow through to exceeds flow through , the regime is laminar therefore all flow from goes via . An oil droplet entering travels into (Fig. 6). A flow through the bridge between and exceeds half of the flow through . Thus, an oil droplet entering also travels into (Fig. 6). When a droplet from enters channels a hydrodynamic resistance of increases. The flow via bridge connecting and becomes less than half of the flow through . The droplet entering travels into channel (Fig. 6).
8 Billiard ball computing with droplets and marbles
Most logical gates implemented in fluidic devices (Sect. 6) and Belousov-Zhabotinsky chemical medium (Sect. 9) utilise the phenomenon of merging colliding jet streams (Fig. 5) and excitation wave-fragments (Fig. 9). Thus, input jet streams or wave-fragments and propagating, beyond the collision site, along their original trajectories represent functions and . A stream or a wave-fragment propagating along new trajectory represents the function . Discrete soft and liquid bodies do not always merge when collide but often reflect. Thus they can implement collision-based gates.
A collision-based computation, emerged from Fredkin-Toffoli conservative logic [59], employs mobile compact finite patterns, which implement computation while interacting with each [15]. Information values (e.g. truth values of logical variables) are given by either absence or presence of the localisations or other parameters of the localisations. These localisations travel in space and perform computation when they collide with each other. Thus the localisations undergo transformations, they change velocities, form bound state and annihilate or fuse when they interact with other localisations. Information values of localisations are transformed as a result of collision and thus a computation is implemented.














When two hard balls collide they reflect in such a manner that a trajectory of a reflected ball is at the angle less than 180o to the trajectories of the same ball not involved in the collision (Fig. 7). If presence of balls represent True values of Boolean variables and then trajectories of the reflected balls represent and . This was an inspiration for the Fredkin gate [59]. When balls are soft they compress on impact and propagate for some period of time as conjunct bodies. Then they restore their shapes and bounce back, thus their output trajectories are shifted in time-space (Fig. 7). When soft bodies impact into each at particular regimes they might merge into a single ball and lose their momentum (Fig. 7): in this case we have only three output trajectories instead of four. The gate shown in Fig. 7 is a fusion gate analogous to Fig. 5.
Outcomes of the collisions between liquid droplets depend on the Weber number of the colliding droplets and their offset. Binary collisions between droplets have been analysed exhaustively by Ashgriz and Poo in 1990 [32] an twenty years later by Rabi et al. [102]. Based on their results we can derive the following experimental droplet gates: stretching separation (Fig. 7) and reflexive separation (Fig. 7) of colliding droplets represent soft balls gate, coalescence of droplets (Fig. 7) is a fusion gate (Fig. 7 and Fig. 5). For certain parameters of the droplet collisions, one or more stationary droplets are formed [32] (Fig. 7), they could represent results of the and gate and even used as elementary memory units (presence of a stationary droplet is a bit up, absence is a bit down).
Mertaniemi et al. [88] explicitly interpreted collisions between droplets on a hydrophobic surface in terms of Boolean logic gates. They programmed trajectories of droplets, and thus architectures of the logical gates, by the geometry of grooves, on the hydrophobic surface, along which the droplets travel. Examples of two gates, the not gate (Fig. 7–7) and the or-and gate (Fig. 7–7). In the not gate (Fig. 7) there is a droplet travelling along channel labelled ‘1’. When this droplet ‘1’ collides with the droplet travelling along the channel , the droplet ‘1’ reflects into south-west channel (Fig.Z7. When input is False and only droplet in channel ‘1’ is present, the droplet ‘1’ travels into the channel . The or-and gate (Fig. 7) shows several channels leaving the collision site thus that the droplets or are always routed to the channel when each of the droplets enters the gate alone (Fig. 7 and 7). When both droplets enter the gate, they collide. Then one droplet enters the channel while other droplet still travels to the channel (Fig. 7).





Instead of running droplets on a hydrophobic surface we can coat the droplets with a hydrophobic power. The droplets then become liquid marbles. The liquid marbles, proposed by Aussillous and Quéré in 2001 [33], are liquid droplets coated by hydrophobic particles at the liquid/air interface (Fig. 8–8). In 2016 Adamatzky proposed to make experimental laboratory prototypes of computing devices allowing the liquid marbles to explore additional degrees of freedom to travel in different directions [13]. First collision based logical gate with liquid marbles was prototypes by Draper et al. [53]. An example of the liquid marble gate in action is shown in Fig. 8.
Computing schemes involving ‘proper’ collision-based gates require a synchronisation of signals. Such synchronisation is indeed achievable but place additional burden on preparation of data for computation; thus, simultaneously with developments of synchronous circuits we considered producing experimental prototypes of asynchronous devices based on cantilever moving parts, actuated by liquid marbles [13].
In 1965 J. T. Goodfrey [64] proposed a mechanical binary digital computer: the configuration of flip-flops arranged on an inclined surface and operated by metal balls rolling down the surface. This design inspired us to prototype an asynchronous binary counter actuated by liquid marbles [54] (Fig. 8).
9 Reaction-diffusion computers
A reaction-diffusion computer [12, 7, 8] is a spatially extended chemical system which processes information by transforming an input concentration profile to an output concentration profile in a deterministic and controlled manner. In reaction-diffusion computers the data are represented by concentration profiles of reagents, information is transferred by propagating diffusive and phase waves, computation is implemented via the interaction of these travelling patterns (diffusive and excitation waves), and results of the computation are recorded as a final concentration profile. Chemical reaction-diffusion computing is amongst the leaders in providing experimental prototypes in the fields of unconventional and nature-inspired computing.

Belousov-Zhabotinsky (BZ) reaction, a periodical oxidation of malonic acid in solution [35, 133, 132], was a key substrate for implementing reaction-diffusion computers in last nearly fort years. In these computing devices an information is represented by travelling oxidation wave fronts (Fig. 9) and the computation is programmed by geometrical constraining of the medium or configurations of the excitation initiation sites.
Research on BZ based information processing has been started in mid-1980s when Kuhnert, Krinsky and Agladze demonstrated that a thing-layer of light-sensitive BZ reaction can implement contrast modification, detection of a contour and smoothing of the half-tone images projected onto the medium [80, 81]. These results ignited an almost forty years epoch of information processing with BZ medium. Works on image processing with BZ continued till early 2000s [30, 29, 103, 104, 106].
In mid-1990s Showalter laboratory produced a series of experimental prototypes of logical gates implemented via interaction of oxidation wave-fronts in geometrically constrained BZ medium [110]. Numerous, modelled and/or implemented in experimental laboratory, devices followed, including signal switches [109], counters [68], one-bit adder [46], many-bit binary adder [134] and decoder [114], three-valued logic gates [94], square root approximation [112].
Designs of potential computing circuits, was facilitated by a discovery of a chemical diode [27]. The diode was made of two plates covered with excitable solution. The corner of the one plate was close to the plane side of another plate. Excitation wave-front travelling in the forward direction reaches the contact site between the plates in a state of a planar wave, it propagates through the contact site and then continues its expanding in the triangular part of the device (Fig. 9). The wave-fragment travelling in the backward direction slows down while propagating towards the corner of the triangular plate (Fig. 9). At the contact point size of the wave-fragment becomes so small, for the level of medium’s excitability, that it annihilates without crossing the contact site between the plates.
The above prototypes constrained BZ medium in templates, that is BZ computers were programmed by architecture. There is another option to realise logical gates in BZ. This is a collision-based, or dynamical, computation [59, 15], see Sect. 8. In 2001 Sendin̈a-Nadal et al.[108] experimentally demonstrated an existence of localised excitations – travelling wave fragments which behave like quasi-particles in the photosensitive sub-excitable BZ medium. In early 2000s we proposed that the compact wave-fragments can represent Boolean values and execute logical gates by colliding with each other [5]. The wave-fragments can be routed in the medium by using non-excitable domains as reflectors (Fig. 9). We employed the localisations to construct several logical gates and circuits [5, 48, 16, 50, 121].
The BZ medium is also used for optimisation tasks, e.g. to assist a maze solving [111, 28, 105] and to calculate a shortest collision-free path [15]. Recently we found that by tuning excitability of the medium we can select critical features of street networks [24, 21]. In excitable BZ, oxidation wave-fronts traverse all streets of the network (Fig. 9). A pruning strategy adopted by the medium with decreasing excitability when wider and ballistically appropriate streets are selected (Fig. 9).
In the early 2000s the first ever excitable chemical controller mounted on-board a wheeled robot was constructed and tested under experimental laboratory conditions [15, 18, 19], and also a robotic hand was interfaced and controlled using a BZ medium [128] (Fig. 9). Litschel et al. [84] shown that by linking micro-reactor with BZ and establishing excitation and inhibitory connections between the neighbouring reactors, it is possible to generate travelling patterns of oscillatory activity resembling the neural locomotive patterns.
Control of a robot with oxidation wave-fronts can be embedded directly in the actuating materials. This can be done by impregnating a pH-sensitive gel with a catalyst and immersing it in the catalyst free BZ solution: a peristaltic motion will be observed [96]; such approach can be advanced to other types of smart materials and soft robots [129, 34].












The collision-based gate shown in Fig. 9 can be also implemented in a geometrically constrained medium, where wave-fragments interact at the junctions of the excitable channels (Fig.10) [9]. In an excitable mode stimulation of a single (Fig. 10, input ) input leads to wave-fronts propagating to all channels. In the sub-excitable mode a wave-fragment from the input channel propagates ballistically to an output channel (Fig. 10) but when both input channels are excited the wave-fragments fuse and propagate into the central vertical channel (Fig. 10). The fusion gates can be cascaded into a one-bit half-adder (Fig. 10–10), and further to a many-bit full adder [9] and Fredkin and Toffoli logically reversible gates [10].
A fine-grained compartmentalisaiton of BZ solutions can be achieved by preparing emulsions or liquid droplets of BZ solution in an oil and liposomes [123, 124, 51, 122, 47, 119, 120]. Then each of the droplets can be seen as computing element interacting with its neighbours via reagents diffusing in oil. Information transmission, as presented by excitation wave fronts, between BZ droplets [119, 69, 120] has been demonstrated in laboratory experiments. Experimental laboratory computing devices made from arrays of BZ droplets or vesicles are the memory devices in BZ-oil emulsion [75] and the nor gate made from BZ droplets with inhibitory coupling [126]. Recently, we demonstrated prototypes of BZ liquid marbles, a BZ solution coated with a hydrophobic powder [61]. There are evidences of oxidation wave-fronts transmission between BZ liquid marbles, possibly via gaseous phase, however more experimental evidences are required to establish design of potential computing architectures.
As demonstrated in computer experiments, by arranging a configuration of BZ droplets and by tuning sizes of pores between BZ vesicles we can implement Boolean gates, including collision-based polymorphic gates [14] and binary arithmetic circuits [23, 74, 73, 17]. In the example shown in Fig. 10 a one-bit half-adder is implemented in a simulated ensemble of two-dimensional BZ vesicles. The outputs from the xor operation are recombined with an or operation with additional discs in the top right. The circuit employs three methods of signal modulation: connection angle, disc size and aperture efficacy. Vesicles sizes and diameters of pores between vesicles are selected intentionally to perform the desired operations. The half-adder implemented in uniformly size vesicles having the same diameters of pores is shown in Fig. 10.
Recently, Gorecki et al. [67] demonstrated how to make a frequency of oscillation based or gate and one-bit memory in an arrays of couple oscillatory BZ droplets and to evolve a classifier of BZ droplets [63].
BZ reaction is not the only chemical medium for unconventional computing. In mid-1990s Adamatzky and Tolmachiov developed prototypes of reaction-diffusion computing devices capable of approximation of Voronoi diagram of a planar point set [118] and calculation of a skeleton of a planar shape [25]. Several experimental laboratory prototypes of precipitating processors have been built for implementation of xor gate [20], computational of a skeleton of a planar shape [20] and Voronoi diagram [49].
10 Discussion
In the past, fluids played a key yet short living role in designs of computing devices. After being outnumbered by electrical analog computers and then digital computers the fluid computers found themselves confined to a narrow range of military applications and control units of nuclear power stations. The liquid based computing, sorting and actuating devices suddenly resurfaced in at a micro-scale, in microfluidics, and in a digital representation, liquid droplets and liquid marbles. In this brief, and possibly subjective, review we touched all principle developments in liquid computing but liquid electronics. Breadth and width of the liquid electronics ‘eco-system’ requires a dedicated review paper. Example ‘species’ of the liquid electronics devices are liquid-solid phase reversible change of conductivity controlled by temperature [135], field controlled electrical switch [127], liquid field effect transistor [76], optical liquid droplet switch [107]. There is a also a huge, and largely unexplored, potential in combining mechanical properties of the liquid jets, droplets and marbles with electrical and optical properties of their solvents and solutes.
References
- [1] A Adamatzky. On dynamics of affective liquids. Dynamical Psychology, 1, 2002.
- [2] AI Adamatzky. Constructing a discrete generalized voronoi diagram in reaction-diffusion media. Neural Network World, 6:635–643, 1994.
- [3] Andrew Adamatzky. Reaction-diffusion computer: Massively parallel chemical computation. In Parcella 1996, VII. International Workshop on Parallel Processing by Cellular Automata and Arrays, Berlin, Germany, September 16-20, 1996, Proceedings, pages 287–290, 1996.
- [4] Andrew Adamatzky. Reaction-diffusion computer: Massively parallel molecular computation. Mathematical Research, 96:287–290, 1996.
- [5] Andrew Adamatzky. Collision-based computing in Belousov–Zhabotinsky medium. Chaos, Solitons & Fractals, 21(5):1259–1264, 2004.
- [6] Andrew Adamatzky. Non-linear dynamics in affective solutions: analysis of massive collectives of emotional agents. Kybernetes, 34(5):652–665, 2005.
- [7] Andrew Adamatzky. Topics in reaction-diffusion computers. Journal of Computational and Theoretical Nanoscience, 8(3):295–303, 2011.
- [8] Andrew Adamatzky. Reaction-diffusion computing. Computational Complexity: Theory, Techniques, and Applications, pages 2594–2610, 2012.
- [9] Andrew Adamatzky. Binary full adder, made of fusion gates, in a subexcitable Belousov-Zhabotinsky system. Physical Review E, 92(3):032811, 2015.
- [10] Andrew Adamatzky. Fredkin and toffoli gates implemented in oregonator model of Belousov–Zhabotinsky medium. International Journal of Bifurcation and Chaos, 27(03):1750041, 2017.
- [11] Andrew Adamatzky. Physical maze solvers. all twelve prototypes implement 1961 lee algorithm. In Emergent Computation, pages 489–504. Springer, 2017.
- [12] Andrew Adamatzky, Benjamin De Lacy Costello, and Tetsuya Asai. Reaction-diffusion computers. Elsevier, 2005.
- [13] Andrew Adamatzky and Ben De Lacy Costello. Computing with liquid marbles. EPSRC Grant EP/P016677/1, 2016.
- [14] Andrew Adamatzky, Ben de Lacy Costello, and Larry Bull. On polymorphic logical gates in subexcitable chemical medium. International Journal of Bifurcation and Chaos, 21(07):1977–1986, 2011.
- [15] Andrew Adamatzky and Benjamin de Lacy Costello. Collision-free path planning in the Belousov-Zhabotinsky medium assisted by a cellular automaton. Naturwissenschaften, 89(10):474–478, 2002.
- [16] Andrew Adamatzky and Benjamin de Lacy Costello. Binary collisions between wave-fragments in a sub-excitable Belousov–Zhabotinsky medium. Chaos, Solitons & Fractals, 34(2):307–315, 2007.
- [17] Andrew Adamatzky, Benjamin De Lacy Costello, Peter Dittrich, Jerzy Gorecki, and Klaus-Peter Zauner. On logical universality of Belousov-Zhabotinsky vesicles. International Journal of General Systems, 43(7):757–769, 2014.
- [18] Andrew Adamatzky, Benjamin De Lacy Costello, Chris Melhuish, and Norman Ratcliffe. Liquid brains for robots. AISB Quarterly, 112(5), 2003.
- [19] Andrew Adamatzky, Benjamin de Lacy Costello, Chris Melhuish, and Norman Ratcliffe. Experimental implementation of mobile robot taxis with onboard Belousov–Zhabotinsky chemical medium. Materials Science and Engineering: C, 24(4):541–548, 2004.
- [20] Andrew Adamatzky, Benjamin de Lacy Costello, and Norman M Ratcliffe. Experimental reaction–diffusion pre-processor for shape recognition. Physics Letters A, 297(5-6):344–352, 2002.
- [21] Andrew Adamatzky and Mohammad Mahdi Dehshibi. Exploring Tehran with excitable medium. arXiv preprint arXiv:1807.09023, 2018.
- [22] Andrew Adamatzky, Owen Holland, N Rambidi, and A Winfield. Wet artificial brains: Towards the chemical control of robot motion by reaction-diffusion and excitable media. In European Conference on Artificial Life, pages 304–313. Springer, 1999.
- [23] Andrew Adamatzky, Julian Holley, Peter Dittrich, Jerzy Gorecki, Ben De Lacy Costello, Klaus-Peter Zauner, and Larry Bull. On architectures of circuits implemented in simulated Belousov–Zhabotinsky droplets. BioSystems, 109(1):72–77, 2012.
- [24] Andrew Adamatzky, Neil Phillips, Roshan Weerasekera, Michail-Antisthenis Tsompanas, and Georgios Ch Sirakoulis. Street map analysis with excitable chemical medium. Physical Review E, 98(1):012306, 2018.
- [25] Andrew Adamatzky and Dmitrii Tolmachiev. Chemical processor for computation of skeleton of planar shape. Advanced Materials for Optics and Electronics, 7(3):135–139, 1997.
- [26] Andy Adamatzky. Parachemistry of mind: Case studies of doxastic and affective mixtures. In Visions of Mind: Architectures for Cognition and Affect, pages 1–20. IGI Global, 2005.
- [27] K Agladze, RR Aliev, T Yamaguchi, and K Yoshikawa. Chemical diode. The Journal of Physical Chemistry, 100(33):13895–13897, 1996.
- [28] K Agladze, N Magome, R Aliev, T Yamaguchi, and K Yoshikawa. Finding the optimal path with the aid of chemical wave. Physica D: Nonlinear Phenomena, 106(3-4):247–254, 1997.
- [29] K Agladze, S Obata, and K Yoshikawa. Phase-shift as a basis of image processing in oscillating chemical medium. Physica D: Nonlinear Phenomena, 84(1-2):238–245, 1995.
- [30] Rubin R Aliev. Oscillation phase dynamics in the Belousov-Zhabotinsky reaction. implementation to image processing. The Journal of Physical Chemistry, 98(15):3999–4002, 1994.
- [31] M Arlazorov. Mashina s vysshem obrazovaniem (a machine with higher education). Ogoniok, 31, 1952.
- [32] N Ashgriz and JY Poo. Coalescence and separation in binary collisions of liquid drops. Journal of Fluid Mechanics, 221:183–204, 1990.
- [33] Pascale Aussillous and David Quéré. Liquid marbles. Nature, 411(6840):924–927, 2001.
- [34] Anna C Balazs and Joanna Aizenberg. Reconfigurable soft matter. Soft matter, 10(9):1244–1245, 2014.
- [35] B.P. Belousov. Periodicheski dejstvuijuschaja reakcia (periodically acting reaction and its mechanism). Sbornik referator po radiatsionnoj medicine. (Collection of reports on radioactive medicine), 147:145, 1959.
- [36] Charles A Belsterling. Fluidic systems design. John Wiley & Sons, 1971.
- [37] Chris Bissell. Historical perspectives-the moniac a hydromechanical analog computer of the 1950s. IEEE Control Systems, 27(1):69–74, 2007.
- [38] Edward Bormashenko, Yelena Bormashenko, Roman Grynyov, Hadas Aharoni, Gene Whyman, and Bernard P Binks. Self-propulsion of liquid marbles: Leidenfrost-like levitation driven by marangoni flow. The Journal of Physical Chemistry C, 119(18):9910–9915, 2015.
- [39] Romald E. Bowles. Passive pure fluid component, June 29 1965. US Patent 3,191,623.
- [40] Jitka Čejková, Taisuke Banno, Martin M Hanczyc, and František Štěpánek. Droplets as liquid robots. Artificial life, 23(4):528–549, 2017.
- [41] Jitka Cejkova, Matej Novak, Frantisek Stepanek, and Martin M Hanczyc. Dynamics of chemotactic droplets in salt concentration gradients. Langmuir, 30(40):11937–11944, 2014.
- [42] Lih Feng Cheow, Levent Yobas, and Dim-Lee Kwong. Digital microfluidics: Droplet based logic gates. Applied Physics Letters, 90(5):054107, 2007.
- [43] A Chiolerio and Marco B Quadrelli. Smart fluid systems: The advent of autonomous liquid robotics. Advanced Science, 4(7):1700036, 2017.
- [44] Joseph Dickerson Clem. The use of the fluid mapper in an investigation of flow into symmetrical openings obstructed by plane surfaces. PhD thesis, Georgia Institute of Technology, 1954.
- [45] Arthur Conway. Guide to Fluidics. Macdonald & Cp. (Publishers) Ltd, 1971.
- [46] Ben De Lacy Costello, Andy Adamatzky, Ishrat Jahan, and Liang Zhang. Towards constructing one-bit binary adder in excitable chemical medium. Chemical Physics, 381(1-3):88–99, 2011.
- [47] Ben De Lacy Costello, Ishrat Jahan, Matt Ahearn, Julian Holley, Larry Bull, and Andrew Adamatzky. Initiation of waves in bz encapsulated vesicles using light-towards design of computing architectures. arXiv preprint arXiv:1212.2244, 2012.
- [48] Benjamin De Lacy Costello and Andrew Adamatzky. Experimental implementation of collision-based gates in Belousov–Zhabotinsky medium. Chaos, Solitons & Fractals, 25(3):535–544, 2005.
- [49] Ben de Lacy Costello, Norman Ratcliffe, Andrew Adamatzky, Alexey L Zanin, Andreas W Liehr, and Hans-Georg Purwins. The formation of voronoi diagrams in chemical and physical systems: experimental findings and theoretical models. International journal of bifurcation and chaos, 14(07):2187–2210, 2004.
- [50] Ben de Lacy Costello, Rita Toth, Christopher Stone, Andrew Adamatzky, and Larry Bull. Implementation of glider guns in the light-sensitive Belousov-Zhabotinsky medium. Physical Review E, 79(2):026114, 2009.
- [51] Jorge Delgado, Ning Li, Marcin Leda, Hector O González-Ochoa, Seth Fraden, and Irving R Epstein. Coupled oscillations in a 1d emulsion of Belousov–Zhabotinsky droplets. Soft Matter, 7(7):3155–3167, 2011.
- [52] Reader Trevor Drake, Jr Arthur J Gehring, and Jacoby Marvin. Pure fluid computer, June 22 1965. US Patent 3,190,554.
- [53] Thomas C Draper, Claire Fullarton, Neil Phillips, Ben PJ De Lacy Costello, and Andrew Adamatzky. Liquid marble interaction gate for collision-based computing. Materials Today, 20(10):561–568, 2017.
- [54] Thomas C Draper, Claire Fullarton, Neil Phillips, Ben PJ de Lacy Costello, and Andrew Adamatzky. Mechanical sequential counting with liquid marbles. In International Conference on Unconventional Computation and Natural Computation, pages 59–71. Springer, 2018.
- [55] Geoffrey William Arnold Dummer and J Mackenzie Robertson. Fluidic Components and Equipment 1968–9: Pergamon Electronics Data Series. Elsevier, 2013.
- [56] Arnold Emch. Two hydraulic methods to extract the n th root of any number. The American Mathematical Monthly, 8(1):10–12, 1901.
- [57] Richard B Fair. Digital microfluidics: is a true lab-on-a-chip possible? Microfluidics and Nanofluidics, 3(3):245–281, 2007.
- [58] JS Frame. Machines for solving algebraic equations. Mathematics of Computation, 1(9):337–353, 1945.
- [59] Edward Fredkin and Tommaso Toffoli. Conservative logic. In Andrew Adamatzky, editor, Collision-Based Computing. Springer, 2002.
- [60] Michael J Fuerstman, Pascal Deschatelets, Ravi Kane, Alexander Schwartz, Paul JA Kenis, John M Deutch, and George M Whitesides. Solving mazes using microfluidic networks. Langmuir, 19(11):4714–4722, 2003.
- [61] Claire Fullarton, Thomas C Draper, Neil Phillips, Ben PJ Costello, and Andrew Adamatzky. Belousov-Zhabotinsky reaction in liquid marbles. arXiv preprint arXiv:1806.07181, 2018.
- [62] D. Gibb. The instrumental solution of numerical equations. In Ellice Martin Horsburgh, editor, Modern Instruments and Methods of Calculation: a Handbook of the Napier Tercentenary Exhibition, pages 259–268. The Royal Society of Edinburgh, 1914.
- [63] Konrad Gizynski, Gerd Gruenert, Peter Dittrich, and Jerzy Gorecki. Evolutionary design of classifiers made of droplets containing a nonlinear chemical medium. Evolutionary computation, 25(4):643–671, 2017.
- [64] John T Godfrey. Binary digital computer, July 2 1968. US Patent 3,390,471.
- [65] AA Golovin, IUP GUPALO, and IUS RIAZANTSEV. The chemothermocapillary effect for drop motion in a fluid (o khemotermokapilliarnom effekte dlia dvizheniia kapli v zhidkosti). Akademiia Nauk SSSR, Doklady, 290(1):35–39, 1986.
- [66] AA Golovin and Yu S Ryazantsev. The drift of reacting drop owing to chemosolutocapillary effect. Izv. Akad. Nauk SSSR, Mekh. Zhidk. Gaza, 3:51, 1990.
- [67] J Gorecki, JN Gorecka, and Andrew Adamatzky. Information coding with frequency of oscillations in Belousov-Zhabotinsky encapsulated disks. Physical Review E, 89(4):042910, 2014.
- [68] J Gorecki, K Yoshikawa, and Y Igarashi. On chemical reactors that can count. The Journal of Physical Chemistry A, 107(10):1664–1669, 2003.
- [69] Gerd Gruenert, Konrad Gizynski, Gabi Escuela, Bashar Ibrahim, Jerzy Gorecki, and Peter Dittrich. Understanding networks of computing chemical droplet neurons based on information flow. International journal of neural systems, 25(07):1450032, 2015.
- [70] Henry Selby Hele-Shaw and Alfred Hay. Lines of induction in a magnetic field. Proceedings of the Royal Society of London, 67(435-441):234–236, 1900.
- [71] HS Hele-Shaw, A Hay, and PH Powell. Hydrodynamical and electromagnetic investigations regarding the magnetic-flux distribution in toothedcore armatures. Journal of the Institution of Electrical Engineers, 34(170):21–37, 1905.
- [72] E. V. Hobbs. Fluid amplification. 9. Logic elements. Technical report, Harry Diamond Laboratories TR-1114, 1963.
- [73] Julian Holley, Andrew Adamatzky, Larry Bull, Ben De Lacy Costello, and Ishrat Jahan. Computational modalities of Belousov–Zhabotinsky encapsulated vesicles. Nano Communication Networks, 2(1):50–61, 2011.
- [74] Julian Holley, Ishrat Jahan, Ben De Lacy Costello, Larry Bull, and Andrew Adamatzky. Logical and arithmetic circuits in Belousov-Zhabotinsky encapsulated disks. Physical Review E, 84(5):056110, 2011.
- [75] Akiko Kaminaga, Vladimir K Vanag, and Irving R Epstein. A reaction–diffusion memory device. Angewandte Chemie International Edition, 45(19):3087–3089, 2006.
- [76] Duk Young Kim, Stephen Herman, and Andrew J Steckl. Iv and gain characteristics of electrowetting-based liquid field effect transistor. In University/Government/Industry Micro/Nano Symposium, 2008. UGIM 2008. 17th Biennial, pages 2–5. IEEE, 2008.
- [77] Joseph M. Kirshner and Silas Katz. Design theory of fluidic components. Academic Press, 1975.
- [78] Hiroyuki Kitahata and Kenichi Yoshikawa. Chemo-mechanical energy transduction through interfacial instability. Physica D: Nonlinear Phenomena, 205(1-4):283–291, 2005.
- [79] Hiroyuki Kitahata, Natsuhiko Yoshinaga, Ken H Nagai, and Yutaka Sumino. Spontaneous motion of a droplet coupled with a chemical wave. Physical Review E, 84(1):015101, 2011.
- [80] L Kuhnert. A new optical photochemical memory device in a light-sensitive chemical active medium. 1986.
- [81] Lothar Kuhnert, KI Agladze, and VI Krinsky. Image processing using light-sensitive chemical waves. 1989.
- [82] István Lagzi, Siowling Soh, Paul J Wesson, Kevin P Browne, and Bartosz A Grzybowski. Maze solving by chemotactic droplets. Journal of the American Chemical Society, 132(4):1198–1199, 2010.
- [83] Veniamin Grigorevich Levich. Physicochemical hydrodynamics. 1962.
- [84] Thomas Litschel, Michael M Norton, Vardges Tserunyan, and Seth Fraden. Engineering reaction–diffusion networks with properties of neural tissue. Lab on a Chip, 18(5):714–722, 2018.
- [85] Petra Lovass, Michal Branicki, Rita Tóth, Artur Braun, Kohta Suzuno, Daishin Ueyama, and István Lagzi. Maze solving using temperature-induced marangoni flow. RSC Advances, 5(60):48563–48568, 2015.
- [86] VS Luk’yanov. Hydraulic instruments for technical calculations. Izveslia Akademia Nauk SSSR, 2, 1939.
- [87] Richard McFee, Robert M Stow, and Franklin D Johnston. Graphic representation of electrocardiographic leads by means of fluid mappers. Circulation, 6(1):21–29, 1952.
- [88] Henrikki Mertaniemi, Robert Forchheimer, Olli Ikkala, and Robin HA Ras. Rebounding droplet-droplet collisions on superhydrophobic surfaces: from the phenomenon to droplet logic. Advanced Materials, 24(42):5738–5743, 2012.
- [89] Shingo Miyazaki, Tatsunari Sakurai, and Hiroyuki Kitahata. Coupling between a chemical wave and motion in a Belousov-Zhabotinsky droplet. Current Physical Chemistry, 5(1):82–90, 2015.
- [90] AD Moore. The hydrocal. Industrial & Engineering Chemistry, 28(6):704–708, 1936.
- [91] AD Moore. Fields from fluid flow mappers. Journal of Applied Physics, 20(8):790–804, 1949.
- [92] Arthur Moore. Arthur d. moore papers: 1916-1984, June Last retrieved 2018.
- [93] Alex JL Morgan, David A Barrow, Andrew Adamatzky, and Martin M Hanczyc. Simple fluidic digital half-adder. arXiv preprint arXiv:1602.01084, 2016.
- [94] Ikuko N Motoike and Andrew Adamatzky. Three-valued logic gates in reaction–diffusion excitable media. Chaos, Solitons & Fractals, 24(1):107–114, 2005.
- [95] Michael J Moylan. Fluid logic in simple terms. The Machinery Publishing Co. Ltd., 1968.
- [96] Yoko Murase, Shingo Maeda, Shuji Hashimoto, and Ryo Yoshida. Design of a mass transport surface utilizing peristaltic motion of a self-oscillating gel. Langmuir, 25(1):483–489, 2008.
- [97] Chin Hong Ooi, Anh Van Nguyen, Geoffrey M Evans, Oleg Gendelman, Edward Bormashenko, and Nam-Trung Nguyen. A floating self-propelling liquid marble containing aqueous ethanol solutions. RSC Advances, 5(122):101006–101012, 2015.
- [98] Frank W Paul. Fluid mechanics of the momentum flueric diode. In IFAC Symposium on Fluidics, Royal Aeronautical Society, Paper A, volume 1, pages 1–15, 1969.
- [99] Maxime Paven, Hiroyuki Mayama, Takafumi Sekido, Hans-Jürgen Butt, Yoshinobu Nakamura, and Syuji Fujii. Light-driven delivery and release of materials using liquid marbles. Advanced Functional Materials, 26(19):3199–3206, 2016.
- [100] Bauer Peter. “and” gate, 1965.
- [101] Manu Prakash and Neil Gershenfeld. Microfluidic bubble logic. Science, 315(5813):832–835, 2007.
- [102] C Rabe, J Malet, and F Feuillebois. Experimental investigation of water droplet binary collisions and description of outcomes with a symmetric weber number. Physics of fluids, 22(4):047101, 2010.
- [103] NG Rambidi, TO-O Kuular, and EE Makhaeva. Information-processing capabilities of chemical reaction–diffusion systems. 1. Belousov–Zhabotinsky media in hydrogel matrices and on solid supports. Advanced Materials for Optics and Electronics, 8(4):163–171, 1998.
- [104] NG Rambidi, KE Shamayaev, and G Yu Peshkov. Image processing using light-sensitive chemical waves. Physics Letters A, 298(5-6):375–382, 2002.
- [105] NG Rambidi and D Yakovenchuk. Chemical reaction-diffusion implementation of finding the shortest paths in a labyrinth. Physical Review E, 63(2):026607, 2001.
- [106] Nicholas G Rambidi. Biologically inspired information processing technologies: reaction-diffusion paradigm. International Journal of Unconventional Computing, 1(2):101, 2005.
- [107] Hongwen Ren and Shin-Tson Wu. Optical switch using a deformable liquid droplet. Optics letters, 35(22):3826–3828, 2010.
- [108] Irene Sendiña-Nadal, Eugene Mihaliuk, Jichang Wang, Vicente Pérez-Muñuzuri, and Kenneth Showalter. Wave propagation in subexcitable media with periodically modulated excitability. Physical review letters, 86(8):1646, 2001.
- [109] Jakub Sielewiesiuk and Jerzy Górecki. Logical functions of a cross junction of excitable chemical media. The Journal of Physical Chemistry A, 105(35):8189–8195, 2001.
- [110] Oliver Steinbock, Petteri Kettunen, and Kenneth Showalter. Chemical wave logic gates. The Journal of Physical Chemistry, 100(49):18970–18975, 1996.
- [111] Oliver Steinbock, Ágota Tóth, and Kenneth Showalter. Navigating complex labyrinths: optimal paths from chemical waves. Science, 267(5199):868–871, 1995.
- [112] William M Stevens, Andrew Adamatzky, Ishrat Jahan, and Ben de Lacy Costello. Time-dependent wave selection for information processing in excitable media. Physical Review E, 85(6):066129, 2012.
- [113] Nobuhiko J Suematsu, Yoshihito Mori, Takashi Amemiya, and Satoshi Nakata. Oscillation of speed of a self-propelled Belousov–Zhabotinsky droplet. The journal of physical chemistry letters, 7(17):3424–3428, 2016.
- [114] Ming-Zhu Sun and Xin Zhao. Multi-bit binary decoder based on Belousov-Zhabotinsky reaction. The Journal of chemical physics, 138(11):114106, 2013.
- [115] Nikola Tesla. Valvular conduit, 1920. US Patent 1,329,559.
- [116] The Polytechnic Museum. Online exhibition. Water computer, 2018. https://polymus.ru/ru/museum/fonds/tours/vodyanoy-kompyuter/#virt-tour-item-4,.
- [117] Michael W Toepke, Vinay V Abhyankar, and David J Beebe. Microfluidic logic gates and timers. Lab on a Chip, 7(11):1449–1453, 2007.
- [118] Dmitrii Tolmachiev and Andrew Adamatzky. Chemical processor for computation of Voronoi diagram. Advanced Functional Materials, 6(4):191–196, 1996.
- [119] Raphaël Tomasi, Jean-Marc Noël, Aymen Zenati, Sandra Ristori, Federico Rossi, Valérie Cabuil, Frédéric Kanoufi, and Ali Abou-Hassan. Chemical communication between liposomes encapsulating a chemical oscillatory reaction. Chemical Science, 5(5):1854–1859, 2014.
- [120] Kristian Torbensen, Federico Rossi, Sandra Ristori, and Ali Abou-Hassan. Chemical communication and dynamics of droplet emulsions in networks of Belousov–Zhabotinsky micro-oscillators produced by microfluidics. Lab on a Chip, 17(7):1179–1189, 2017.
- [121] Rita Toth, Christopher Stone, Ben de Lacy Costello, Andrew Adamatzky, and Larry Bull. Simple collision-based chemical logic gates with adaptive computing. Theoretical and Technological Advancements in Nanotechnology and Molecular Computation: Interdisciplinary Gains: Interdisciplinary Gains, page 162, 2010.
- [122] Vladimir K Vanag and Irving R Epstein. Excitatory and inhibitory coupling in a one-dimensional array of Belousov-Zhabotinsky micro-oscillators: Theory. Physical Review E, 84(6):066209, 2011.
- [123] Vladimir K Vanag and Ichiro Hanazaki. ph dependence of the Belousov- Zhabotinsky reaction in water-in-oil reverse microemulsion of aot in octane. The Journal of Physical Chemistry, 100(25):10609–10614, 1996.
- [124] Vladimir Karlovich Vanag. Waves and patterns in reaction–diffusion systems. Belousov–Zhabotinsky reaction in water-in-oil microemulsions. Physics-Uspekhi, 47(9):923–941, 2004.
- [125] Manuel G. Velarde. Drops, liquid layers and the marangoni effect. Philosophical Transactions Royal Society of London. Series A: Mathematical, Physical and Engineering Sciences, 356:829–842, 1998.
- [126] AL Wang, JM Gold, N Tompkins, M Heymann, KI Harrington, and S Fraden. Configurable nor gate arrays from Belousov-Zhabotinsky micro-droplets. The European Physical Journal Special Topics, 225(1):211–227, 2016.
- [127] James Wissman, Michael D Dickey, and Carmel Majidi. Field-controlled electrical switch with liquid metal. Advanced Science, 4(12):1700169, 2017.
- [128] Hiroshi Yokoi, Andy Adamatzky, Ben de Lacy Costello, and Chris Melhuish. Excitable chemical medium controller for a robotic hand: Closed-loop experiments. International Journal of Bifurcation and Chaos, 14(09):3347–3354, 2004.
- [129] Ryo Yoshida. Self-oscillating gels driven by the Belousov–Zhabotinsky reaction as novel smart materials. Advanced Materials, 22(31):3463–3483, 2010.
- [130] Natsuhiko Yoshinaga. Spontaneous motion and deformation of a self-propelled droplet. Physical Review E, 89(1):012913, 2014.
- [131] NO Young, JS Goldstein, and Mi J Block. The motion of bubbles in a vertical temperature gradient. Journal of Fluid Mechanics, 6(3):350–356, 1959.
- [132] AN Zaikin and AM Zhabotinsky. Concentration wave propagation in two-dimensional liquid-phase self-oscillating system. Nature, 225(5232):535, 1970.
- [133] Anatol M Zhabotinsky. Periodical oxidation of malonic acid in solution (a study of the Belousov reaction kinetics). Biofizika, 9:306–311, 1964.
- [134] Guo-Mao Zhang, Ieong Wong, Meng-Ta Chou, and Xin Zhao. Towards constructing multi-bit binary adder based on Belousov-Zhabotinsky reaction. The Journal of chemical physics, 136(16):164108, 2012.
- [135] Ruiting Zheng, Jinwei Gao, Jianjian Wang, and Gang Chen. Reversible temperature regulation of electrical and thermal conductivity using liquid–solid phase transitions. Nature communications, 2:289, 2011.